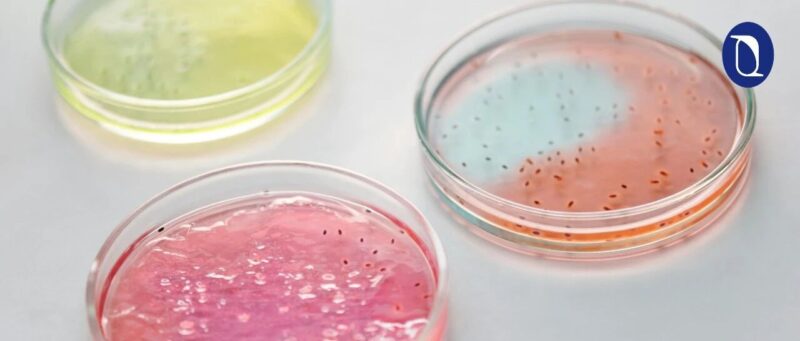
我们能在培养皿里制造出意识吗？-AI Express News

最新发布第5页
排序
MiniMax Office Skills:开源一套生产级办公文档引擎
M2.7 开启了模型的自我进化,是我们第一个模型深度参与迭代自己的模型。在专业办公领域,M2.7 对 Office 三件套 Excel/PPT/Word 的复杂编辑能力有了显著提升,能更好地完成多轮修改和高保真的编...
一人公司 (OPC) 创业必备的 9 个 Agent Skills
Gumroad 创始人 Sahil Lavingia 把他的著名书籍「The Minimalist Entrepreneur」中的极简创业哲学封装为 9 个 Agent Skills,让 Agent 做可交互的 AI 创业教练!
苹果国行AI凌晨突发上线后被撤下/雷军亲自官宣招募AI人才/6999起,vivo X300 Ultra正式发布
· 张雪机车 WSBK 葡萄牙站两连冠,中国摩托首破欧美日垄断x0dx0a· 苹果开源编程语言 Swift 正式支持 Androidx0dx0a· ClawBench 最新榜单:智谱 GLM-5-Turbo 登顶
人类一离座AI就进化!伯克利开源MetaClaw,静态Agent慌了
新智元报道 编辑:元宇 【新智元导读】你开会时,AI竟在偷偷升级?伯克利等四校开源MetaClaw,让Agent趁你开会、离席、睡觉时持续进化,直接打破「上线即冻结」这条行业铁律。 又到了...